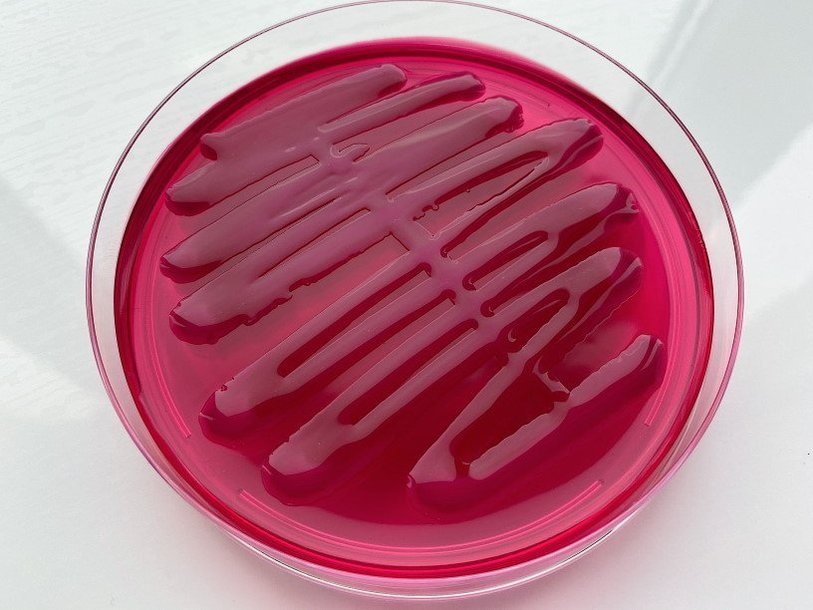

Екатерина Беленко: Промикробы: Кончится пленка
Фото: Екатерина Беленко
Фото: Екатерина Беленко Про то, что бактерии могут, любят и умеют образовывать колонии на чашках Петри, я вам уже все уши прожужжала. А сегодня пожужжу про другой способ коллективизации бактерий — биопленки.
⠀
Биопленка — это множество микроорганизмов, расположенных на какой-либо поверхности, клетки которых прикреплены друг к другу. Обычно клетки погружены в выделяемое ими внеклеточное полимерное вещество, оно же внеклеточный матрикс, оно же слизь. Получается, что биопленка — это обладающая пространственной и метаболической структурой необычная колония микроорганизмов, погруженных во внеклеточный полимерный матрикс. Поверхность, к которой прикреплена биопленка, может быть как неживой (камни), так и поверхностью живого организма (стенки кишечника, зубы).
⠀
Мы, многоклеточные, далеко не всегда знали об этом умении бактерий. И чем лучше мы изучаем вопрос, тем более распространенным оказывается умение объединяться в плоские группировки. Сейчас считается, что 95–99 % всех микроорганизмов в естественной среде существует в виде биопленки. Сразу хочу предупредить, что на фото не биопленка, а просто обильный рост, максимально слизнявый на вид, чтобы было в тему.
⠀
Итак, чем же страшны биопленки, если они вдруг оказались внутри вас? А тем, что сложнее вылечиться, так как броня из слизи не дает антибиотикам делать свое дело. Лечение антибиотиками может иметь эффект на бактерии в планктонной фазе, которые высвобождаются биопленкой и являются причиной инфекционных обострений, но не в состоянии устранить устойчивое бактериальное сообщество, содержащееся в ней. Про планктонную фазу, думаю, вы поняли — это бактерии, плавающие в просвете органа, как рачки в океане. Например, часты случаи образования биопленок кишечной палочкой в мочевом пузыре и во влагалище. А это приводит к хроническим рецидивирующим инфекциям, не самое приятное соседство. Кроме того, раз уж мы затронули гинекологическую тему, биопленка может быть образована на поверхности таких предметов, как противозачаточные кольца и другие контрацептивные имплантаты.
⠀
Если патогенные микроорганизмы создают биопленку в мочевом пузыре, это может вызвать хронический цистит с острыми эпизодами каждый раз, когда вскрывается биопленка. Терапия антибиотиками в этом случае опять же малоэффективна. Патогенные биопленки, типичные для мочевого пузыря, характеризуются уропатогенными штаммами Escherichia coli, ответственными за 75–85 % рецидивирующего цистита. Но не думайте, что только урогенитальной областью ограничиваются биопленочные захватчики. За образование зубного налета, развитие гингивита, кариеса и пародонтоз тоже ответственны именно они. Поэтому после прочтения этой статьи все дружно идем чистить зубы.
Смотрите также: Екатерина Беленко Промикробы: Броня крепка Екатерина Беленко Промикробы: Опасный сосед Екатерина Беленко Промикробы: Повышенная влажность Екатерина Беленко Промикробы: Некоторые любят погорячее